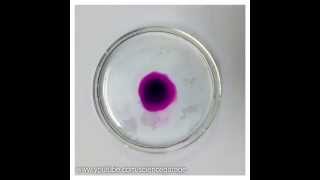
Potassium Permanganate Diffusion (Time Lapse)

Science4Breakfast
Diffusion Experiment Using Agar Cubes #chemistry #gcsescience
1 year ago - 0:26

FlemDog Science
Best Diffusion Experiment Ever! (Maybe...)
2 years ago - 6:47

Nigel Baldwin
Ammonia and hydrogen chloride diffusion experiment
7 years ago - 3:05

igor30
Diffusion and Temperature: Water & Pen ink & Vinegar
11 years ago - 1:20

Science North
Diffusion and Osmosis - For Teachers
9 years ago - 8:34

JamJarMMX
GCSE Science Revision - Diffusion of Gases
13 years ago - 4:01

sciencefix
Food Coloring Diffusion
15 years ago - 0:40

Sparking STEM
Diffusion with potassium permanganate - science lesson
3 years ago - 4:15

Nix Makes
The Misconception About Diffusion | Diffusion Experiment Done Right
3 years ago - 5:56

Ashley Masters
Diffusion Lab with Starch and Iodine 2020
5 years ago - 6:44

It's AumSum Time
Diffusion - Why can we smell hot food from a distance? | #aumsum #kids #science #education #children
8 years ago - 2:09

Kont Kont
Diffusion of Food Dye In Hot & Cold & Warm Water
7 years ago - 1:07

Taleem n Tarbiyah
The Science behind diffusion: Hot vs Cold water experiment
2 years ago - 0:25

Ace
General Biology activity: Diffusion and Osmosis
6 years ago - 3:38

Aaron LAB
Diffusion of ink in pure 💧 water#experiment #science#water
2 years ago - 0:15

magnet star
diffusion of particle#scienceexperiment#chemistry#shortsfeed#tranding #magnetstar#shorts
2 years ago - 0:22

FlemDog Science
Best Diffusion Experiment Ever (maybe)...Full Video in Comments!
2 years ago - 0:53

Dk Studentoo
Diffusion experiment #shorts #lifehacks
2 years ago - 0:31

Elearnin
Diffusion and Osmosis | Iodine starch experiment with bag | Science Experiments | elearnin
12 years ago - 3:03

It's AumSum Time
Diffusion | #aumsum #kids #science #education #children
10 years ago - 3:32

SciLabX
Hot vs Cold Water 🔥❄️ Diffusion Experiment! #scienceexperiment #shorts #diffusion #visualscience
7 months ago - 0:14

D. Kovanda
Diffusion demonstration - agar in vinegar
6 years ago - 0:08

Shannan Muskopf
Set-Up of Diffusion Lab (Cornstarch & Iodine)
5 years ago - 1:24

Cognito
What is Diffusion? How Does it Work? What Factors Affect it? (2026/27 exams)
5 years ago - 5:18

Medhavi's Learning
Osmosis | Science Experiment | #shorts #experiment #osmosis #diffusion #asmr #trending #science
1 year ago - 0:22

The Elkchemist
Diffusion | Potassium Manganate (VII) Hot & Cold #chemistry #experiment
3 years ago - 0:31

Science Garage
Potassium Permanganate Diffusion (Time Lapse)
11 years ago - 0:32

Alperen Topal
Exploring the Diffusion of Water with Tea Bags
8 months ago - 0:47

Latha channel
Diffusion / easy science experiment
1 year ago - 1:01

TECH Genius
Unveiling Osmosis Secrets: A Sugar Water Diffusion Experiment with a Surprise
2 years ago - 0:45

magnet star
ink diffusion in water | science experimentnt#physics#shortsfeed#tranding#magnetstar#shorts
2 years ago - 0:24

Bozeman Science
AP Biology Lab 1: Diffusion and Osmosis
13 years ago - 7:45

Julian Buss
Diffusion of Water, Glucose, and Starch through a Dialysis Bag
5 years ago - 9:41

Mum Jay's World
Diffusion in Fresh Water Vs Salt Water#shorts#science
2 years ago - 0:50

Rahul Shwetha
Food colouring diffusion in normal and salt water experiment/ #experiment /#shorts/#science
4 years ago - 0:26

Abhishek Sir Rewa
Concept of diffusion #physicsfun #viral #physicsexperiment #ytshorts #youtubeshorts #shorts
1 year ago - 0:51

Study Experiments
Diffusion In Water Experiment #ytshorts #studyexperiments
3 months ago - 0:15

MVTutoring
Diffusion practical - agar jelly with various surface area to volume ratios
5 years ago - 4:16

Science and fun
Race toh main hi jeetunga 😂 #scienceandfun #diffusion #experiment #ashusir #shorts
1 year ago - 1:00

Kitchen Lab
DIY Diffusion Experiment
10 months ago - 0:38

experiment eneargy
salt water and potato experiment #schoolexperiment #experiment #scienceexperiments
2 years ago - 0:18

Supriya Rai
Diffusion|Matter in our Surrounding|Diffusion Experiment #diffusionexperiment#science #scienceclass9
9 months ago - 0:35

Academic Wizard
Diffusion practical | science experiment #science #fun #study #viralexperiments
2 years ago - 0:52

The Emergent Classes
Mixing Ink in Hot vs. Cold Water: A Color Diffusion Experiment.
1 year ago - 0:52

Mr. G Physics
How does temperature affect diffusion?
2 years ago - 0:30

Medhavi's Learning
Osmosis | Science Experiment | #shorts #experiment #osmosis #diffusion #asmr #trending #science
1 year ago - 0:22

Exons Talk
Is DIY Diffusion Worth It? #experiment
1 year ago - 0:11

Shree Ram Educators
Diffusion rate comparison Class 9 #scienceexperiment #Science
2 years ago - 0:20

Sharma Classes
Diffusion Experiment with Indigo(Nil)
3 years ago - 0:46

Infinity Classes Aadi Sir
What is diffusion? | Hot and Cold water experiment #shorts #matterinoursurroundingsclass9 #science
2 years ago - 0:47

chemistry teacher
Diffusion experiment. #igcse #diffusion #chemistry #edexcel #matric #fun #kidsvideos
1 year ago - 0:20

scarymonster😈
diffusion easy science experiments at home water ink #ytshort#youtubeshorts#easyexperiment#shorts
2 years ago - 0:23

Everyday Science Tricks
The Colorful Science of Diffusion: The Milk and Food Coloring Experiment
7 months ago - 0:47

Mr. G Physics
How does temperature affect diffusion?
2 years ago - 0:30

ROOT CLASSES
diffusion || matter in our surrounding #class9science #rootclasses #scienceexperiment #cbse
3 years ago - 0:15

Science Ideas 101
Diffusion in hot water is much faster ❤️ Simple Experiment #simpleexperiments #shorts #ytshorts
1 day ago - 0:17

Science Class
The Effect of Temperature on the Rate of Diffusion
1 year ago - 2:24

Mash Albert
"How Sugar Changes Water Physics | Color Diffusion Experiment" 🤔🤔 #shorts #youtubeshorts
7 months ago - 0:29

experimentbyworld
experiments diffusion #experiment #diffusion #energy
2 years ago - 0:58

Teaching Video srv 6m
diffusion ||matter in our surrounding#class9science #rootclasses#scieence #experiment
7 months ago - 0:22

Mr. Clark Science
Egg Cell Osmosis! #experiment #science #diffusion
1 year ago - 0:23

RegisteredNurseRN
Cell Membrane Transport (Passive & Active) Diffusion, Osmosis, Hydrostatic Oncotic Pressure Colloid
2 years ago - 13:55

kawan speak
colour spread in water due to diffusion science experiment 😍#scienceexperiment #colour#diffusion
2 years ago - 0:11

SCIENCE ZONE
diffusion of matter...depend on the temperature 🌡 #class9#experiment #experiements #class10th
5 months ago - 0:15

SCIENCE CLUB
diffusion of bromine vapour #chemistry #periodictable #experiment #gas #laws
1 year ago - 0:58

DSRM Exploring Vigyan
Diffusion #diffusion #kineticenergy #kinematics #class9science #class11chemistry #physicsexperiment
4 months ago - 0:16

Home Lab Heroes
Drift of the Diffusion: A Gelatin Color Experiment
4 months ago - 0:42